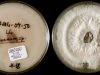
Two Killed by Contaminated Surgeries in Mexico, 206 Others at Risk of Brain Infections in the US “Two Killed by Contaminated Surgeries in Mexico, 206 Others at Risk of Brain Infections in the US”

Hold on tight! Even the biggest stars aren’t always safe in the vastness of space. Imagine a star three times the size of our own, getting too close to a massive black hole. The black hole’s powerful gravity tears the star apart, scattering its remains across the cosmic landscape like a crime scene.
What makes this event, known as ASASSN-14li, even more intriguing is that it happened a mere 290 million light-years away from Earth. That might sound far, but in cosmic terms, it’s relatively close. Initially mistaken for a supernova, ASASSN-14li has captivated astronomers since its discovery in 2014. It could potentially be the largest star ever devoured by a black hole. Now, a new forensic analysis sheds more light on this stellar victim.
Exhibit A
Unraveling the mystery of ASASSN-14li required the research team to think like cosmic medical examiners. They turned to data from NASA’s Chandra and ESA’s XMM-Newton X-ray telescopes. When a star is torn apart by a black hole’s gravitational forces, the remaining debris becomes intensely heated, resulting in a powerful flare. These flares can be observed in X-rays, as well as visible and ultraviolet light.
During the flare, the black hole’s accretion disk rapidly draws in gas from the shattered star, releasing energy in the process. This phenomenon, observed by Chandra and XMM-Newton, is a rare occurrence since most stars devoured by black holes are smaller and contain less gas.
Advertisement
By observing the event in X-ray wavelengths, the telescopes detected the presence of carbon and nitrogen in the black hole’s accretion disk. Comparing the levels of these elements to those in the Sun allowed scientists to estimate the star’s mass. Heavier stars, like the one in ASASSN-14li, contain more nitrogen than carbon due to their fusion processes.
Previous simulations couldn’t determine whether the nitrogen and carbon in the accretion disk came from a high-mass star or a lower-mass star that had shed its outer layers. However, the gas in ASASSN-14li’s accretion disk had nitrogen levels up to 100 times higher than the Sun’s and significantly lower carbon levels. This suggests that the black hole devoured a star approximately three times the mass of our Sun.
Future investigations
This groundbreaking discovery by Ramirez-Ruiz and his team provides crucial evidence about the mass of the unfortunate star in ASASSN-14li. It opens up new possibilities for identifying and studying massive stars destroyed by black holes. Stars with similar masses to ASASSN-14li could exist in clusters near supermassive black holes, such as Sagittarius A* in our own galaxy. If this is the case in other galaxies, there may be more tidal disruption events involving massive stars than previously believed. It’s a cosmic mystery waiting to be solved.
Source: Astrophysical Journal Letters, 2023. DOI: 10.3847/2041-8213/ace03c
Astronomers have long suspected that monster black holes have the power to dramatically alter galaxies. Now, a group of researchers has unveiled evidence of its devastating effects on a star, providing simple yet powerful insights into how supermassive black holes shape the galaxies that they inhabit.
The research, conducted by an international team of astronomers led by Erini Lambrides from the Australian National University in Canberra, studied a star in the Milky Way’s Galactic Center, and was recently published in the journal Nature.
The star, dubbed G2, used to orbit a supermassive black hole, known as Sagittarius A*. Its orbit was so close to the black hole that it experienced extreme tides and gravitational forces that tore it apart.
The astronomers observed the star’s remains, which are being pulled away from the black hole by its strong gravitational forces, and noted that they were traveling at a very high speed- around 3,000 kilometers/second. This showed that the black hole’s tug had accelerated the star’s remains faster than expected.
Further analysis revealed that the star had been totally disrupted by the black hole, with only half of it remaining. The team believe that the other half of the star had been swallowed by the black hole.
The observations of G2 offer the most direct evidence yet that supermassive black holes can have a powerful and devastating influence on their surrounding galaxies. They also demonstrate how powerful gravitational forces can accelerate stars to near-light speed, a phenomenon that was previously only speculated about.
The study of G2 also provides a glimpse into what happened during the merging of galaxies in the early Universe, many of which likely hosted monster black holes that shredded and swallowed entire stars.
This research provides invaluable insight into how galaxies form and evolve over time, and suggests that monster black holes may have played a huge role in galactic history.